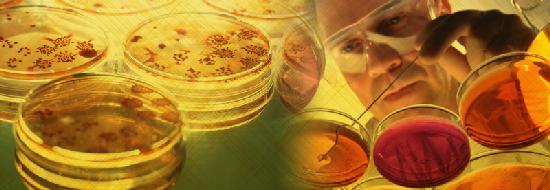

Классификация
Большинство микозов (более 90%) вызваны заражением грибковыми микроорганизмами из семейства Candida. Тем не менее, существуют и другие возбудители, способные вызывать подобные проблемы. В зависимости от этого, можно выделить следующие типы заболеваний:
- Кандидоз – это самый известный и распространенный вид грибковых микроорганизмов. Он заражает носовую полость, попадая в организм воздушно-капельным путем, через руки, продукты питания или почву. При этом на пораженных участках слизистой появляется специфический налет и запах. Также данная форма заболевания сопровождается выраженным зудом. При правильном и своевременном лечении этот вид микоза не представляет никаких опасностей для человека.
- Мукоромикоз – этот вид инфекции попадает на слизистые оболочки во время дыхания. При отсутствии адекватной терапии есть риск утолщения оболочки, покрывающей стенки носового прохода. Это создает сложности с поступлением в организм кислорода. В более редких случаях мукоромикоз провоцирует разрушение структуры костей околоносовых пазух. В 70 % случаев этот вид микоза возникает на фоне сахарного диабета. Эта патология создает благоприятные условия для активного развития грибков. Благодаря этому они могут закрепиться на поверхности слизистых оболочек, что позволит им быстро размножаться.
- Аспергиллез – медики выделяют две разновидности этой инфекции. Она попадает на слизистые покровы вместе с пылью. Инвазивный вид патологии может приводить к появлению злокачественных опухолей. При неинвазивной форме недуга есть риск обструкции носовых пазух. Это провоцирует интенсивную боль в лицевой части.
- Гистоплазмоз – грибковая инфекция попадает в носовую полость вместе с пылью. Однако в этом случае наблюдаются менее опасные последствия, чем при аспергиллезе. При этом запущенные случаи нарушения могут стать причиной формирования язвенных дефектов. Это приводит к нарушению строения перегородок носа.
- Риноспоридиоз – слизистая носа поражается при попадании на нее возбудителей инфекции с водой или пылью. При этом создаются благоприятные условия для развития полипов. Это становится причиной кровотечений из носа, заложенности, появления гнусавости голоса, болевых ощущений и ринита. Справиться с данной разновидностью патологии удастся только оперативным путем.
- Бластомикоз – развивается при заражении отдельными разновидностями диморфных грибков. Патология приводит к образованию в носу специфических язв.
Способы лечения
Лечение грибкового ринита должно быть всесторонним, включая применение препаратов против грибков, облегчение симптомов и воздействие на причину заболевания, а также использование традиционных методов медицины. Это способствует преодолению инфекции и предотвращению ее рецидива.
Необходимо также укрепить защитные силы организма, что поможет предотвратить повторное заражение в будущем. Полезными будут процедуры физиотерапии, направленные на улучшение кровообращения в тканях носа и восстановление его слизистой оболочки.
Терапия препаратами
Выбор препаратов, которые уничтожают грибковую инфекцию, зависит от вида возбудителя и его чувствительности к различным препаратам. При кандидозе ротоглотки и носа чаще всего применяются «Флюконазол», «Имидазол» и другие антимикотики. Кроме того, пациентам рекомендуются средства для местного воздействия, которые способствуют снижению воспаления и устранению отека слизистой носа. Для этого используются антигистаминные, нестероидные противовоспалительные и гормональные препараты. Также проводится десенсибилизирующая терапия, направленная на уменьшение чувствительности иммунной системы к аллергенам. Рекомендуется также применение иммунных комплексов, так как они способствуют улучшению реактивности иммунитета.
Народные рецепты
Для лечения грибкового поражения слизистой оболочки носа часто применяется раствор натрия бикарбоната.
Средства альтернативной медицины легки в использовании, доступны и не требуют финансовых затрат, поэтому они популярны среди людей. Эффективным методом борьбы с грибковым ринитом является процедура промывания носа раствором соды, которая способствует уменьшению отечности и устранению зуда. Также полезно промывать нос настоем ромашки, шиповника и календулы. Кроме того, можно наносить на слизистую оболочку носа соки моркови и свеклы, что способствует улучшению процесса регенерации тканей.
Виды грибкового ринита
В настоящее время известно несколько разновидностей грибковых инфекций, направленных на нос в качестве своей цели.

Иногда эффективное лечение невозможно без точной идентификации возбудителя, даже если симптомы очень похожи. Среди распространенных грибков, поражающих носовую полость, можно выделить:
- Аспергиллез. Вызывает эту болезнь несколько видов плесневых грибков, известных как аспергиллы. Они обитают в различных местах внешней среды, таких как гниющие овощи и фрукты, а также зерно. Заражение происходит при вдыхании их спор. Этот микоз имеет две формы — инвазивную и неинвазивную. Первая, если не получает соответствующего лечения, может привести к развитию злокачественных опухолей, а вторая может привести к непроходимости носовых пазух.
- Бластомикоз. Это заболевание развивается в легких и распространяется по организму с кровотоком. В этом случае язвы не затрагивают слизистую, но зато влияют на кожу носа.
- Гистоплазмоз — вторая инфекция, которая попадает в организм только через пыль. Последствия в этом случае не так страшны, но если грибок затрагивает нос, то могут возникнуть язвы, а затем дефекты в строении перегородок.
- Кандидоз является самым распространенным видом микозов (90% от всех случаев). Это связано с различными путями проникновения в организм человека. Грибок рода Кандида распространяется воздушным путем, через контакт, обитает в почве и продуктах питания. Некоторые специалисты полагают, что он изначально присутствует в организме почти каждого человека. Болезнь можно распознать по творожистым выделениям из носа.
- Мукоромикоз. Возбудителями являются плесневые грибки. Передается воздушно-капельным путем. Он предпочитает диабетиков, у которых встречается в 70% случаев. Без лечения слизистая утолщается, что приводит к заложенности носовых пазух. В редких случаях происходит разрушение костной ткани.
- Риноспоридиоз изучен слабо. Известно, что этот грибок обитает в пыли и воде. Без адекватного лечения в носу образуются полипы, вызывающие неприятные симптомы, такие как затруднение дыхания, длительный насморк и кровотечения.
Первые признаки грибка в носу очень похожи на обычную простуду — сонливость, слабость и повышение температуры. Единственное отличие — бесполезность сосудосуживающих препаратов. Когда состояние ухудшается, появляются характерные симптомы:
- неприятное покалывание в носу, которое постепенно усиливается;
- постоянное ощущение сухости в носу;
- дискомфорт и болезненные ощущения в области горла;
- непрерывные приступы чихания;
- обильное выделение слизи, которое имеет необычный оттенок и запах.
Если насморк не проходит более недели, и лекарства приносят временное облегчение, то стоит обратить внимание на возможное наличие грибка в носу и обратиться к врачу для консультации.
Виды грибковых инфекций слизистой носа и их диагностика
Для выявления грибковой инфекции слизистой носа проводят культуральные исследования соскоба и анализ пораженных тканей под микроскопом.
Выполнение всех указанных процедур возможно только при участии опытного врача-оториноларинголога в клинической или стационарной среде. Этих медицинских исследований, как правило, достаточно для того, чтобы не только выявить грибковую инфекцию в носу, фотографии которой можно найти в сети, но и точно определить ее вид. Это важно для успешного назначения лечения.
Наиболее часто при грибковом рините выявляются следующие заболевания:
- Мукоромикоз. Его возбудители распространены повсеместно и попадают на слизистую носа во время дыхания. Не лечить этот недуг может привести к утолщению слизистой оболочки носовых ходов и, в некоторых случаях, к разрушению кости околоносовых пазух.
- Кандидоз. Грибки рода Кандида хорошо известны женщинам, так как они вызывают самое распространенное заболевание женской половой сферы – молочницу. Они также могут поражать слизистую оболочку носа, вызывая характерный налет, зуд и неприятный запах.
- Гистоплазмоз. Его возбудители присутствуют в пыли и также могут попадать в наш нос при дыхании. Это заболевание может привести к появлению болезненных язв, поражающих носовые перегородки и другие области.
- Аспергиллез неинвазивного и инвазивного вида. Этот недуг может быть вызван 3 видами грибов, которые обитают в пыли. Инвазивная форма опасна возможным озлокачествлением процесса и требует немедленного оперативного лечения, а неинвазивная форма вызывает обструкцию носа и сильные боли в области лица.
- Риноспоридиоз. Это заболевание вызывается малоизученным грибком, который попадает на слизистую из пыли или воды. Оно опасно в первую очередь появлением множественных полипов на носовой перегородке, которые вызывают кровотечение, обильный насморк, обструкцию и изменение звучания голоса.
При выявлении грибка в носу, лечение подбирается с трудом из-за сложности подбора соответствующих препаратов и требует точного определения возбудителя инфекции и окончательной постановки диагноза.
Эффективные народные средства
Помимо обычных методов лечения, можно использовать эффективные народные средства. В настоящее время существует большое количество домашних рецептов, которые помогают быстро избавиться от неприятного заболевания. Среди них следующие:
- Промывание носа при помощи отваров из растений. Для борьбы с грибковой инфекцией рекомендуется использовать препараты, содержащие ромашку, череду и календулу. Также эффективными считаются дубовая кора и цветки шиповника. Для приготовления полезного средства необходимо смешать 1 ложку сушеного растения с 1 стаканом кипятка, настоять полученную смесь минимум 2-3 часа, профильтровать и использовать несколько раз в день для полоскания носа.
- Лечение слизистой оболочки носа морковным и свекольным соком. Эти средства можно применять для обработки пораженных участков слизистой оболочки несколько раз в сутки.
- Использование содового раствора для полоскания. Для приготовления полезного продукта необходимо растворить половину небольшой ложки соды в 500 мл теплой воды. Готовым составом следует промывать полость носа, используя большой шприц без иглы.
- Для стимуляции заживления слизистых оболочек рекомендуется смешать по 1 ложке сока алоэ и витамина А, затем обработать пораженные участки этим средством.
Грибковые патологии ЛОР-органов
Различение грибковых заболеваний происходит в зависимости от того, какой конкретно микроорганизм вызвал развитие болезни.
Молочница
Самой частой грибковой болезнью является кандидоз, вызванный дрожжеподобными грибками из семейства Кандида. Важно отметить, что кандидоз затрагивает не только половые органы, но также слизистую оболочку органов ЛОР-системы и пищеварительного тракта.
Мукоромикоз
Мукоромикоз представляет собой серьезное грибковое заболевание, вызванное плесневыми грибками. Оно чаще всего наблюдается у пациентов с begleitenden тяжелыми хроническими заболеваниями – такими как тонзиллит, патологии ЖКТ и эндокринные нарушения.
Аспергиллез
Патогенные грибы аспергиллы вызывают данное заболевание. Чаще всего эти микроорганизмы поражают слизистые оболочки органов ЛОР и дыхательные пути, но в продвинутых случаях могут вызвать воспалительные процессы в любом органе.
Существует два вида заболеваний:
- Неагрессивный. Затрагивает только слизистую оболочку носового хода или околоносовую пазуху.
- Агрессивный. В данном случае воспалительный процесс распространяется на кости, дыхательные пути, внутренние органы.
Риноспоридоз
Необычное длительное тропическое заболевание, проявляющееся воспалительным процессом слизистой оболочки носоглотки и образованием папилломатозных опухолей.
При риноспоридиозе образования на слизистой напоминают форму «ягод малины» или «кочанов капусты».
Гистоплазмоз
Гистоплазмоз, также известный как болезнь Дарлинга, вызывается определенными грибковыми организмами, которые попадают в носовые ходы человека при вдыхании загрязненного воздуха, что приводит к образованию язв и эрозий.
Людям с нарушениями иммунной системы болезнь может затронуть внутренние органы, вызвать серьезное воспаление и даже привести к летальному исходу.
Грибковый ринит
У людей с ослабленным иммунитетом грибковый ринит приводит к повреждению передней и средней части перегородки носа и образованию длительно не заживающих язв.
Инфекция в носовой полости чаще возникает у людей пожилого возраста, а также у тех, кто имеет ослабленный иммунитет. Признаки этого заболевания похожи на обычный насморк, однако они длительные и не реагируют на обычные лекарства.
Способы терапии
Лечение инфекции в носовой полости требует комплексного и последовательного подхода. Врачи обычно назначают системные противогрибковые препараты, местные лекарства и симптоматическую терапию (включая деконгестанты, препараты для облегчения дыхания и противозудные средства). Также проводится коррекция нарушений, которые могут привести к снижению иммунитета и появлению грибковой инфекции.
Системные препараты
Для лечения грибковой инфекции применяются эффективные противогрибковые средства, такие как Флуконазол, Вориконазол, Нистатин, Клотримазол и другие. Выбор конкретного препарата зависит от вида грибка, вызвавшего заболевание, а также его чувствительности к антимикотическим препаратам. Степень запущенности заболевания определяет способ введения препаратов.
При наличии серьезной грибковой инфекции в условиях сниженного иммунитета, предпочтительным является использование внутривенного способа введения лекарств.
Для лечения грибковых инфекций умеренной тяжести и в период восстановления рекомендуется прибегать к приему препаратов в виде таблеток.
При незначительном проявлении грибкового воспаления медики рекомендуют применение специальных капель и мазей.
Противогрибковые капли
Болезни легких обычно поддаются лечению с использованием противогрибковых капель, содержащих Флуконазол. Также используются капли Микроспор, Кандид и Клотримазол.
Окомистин, дезинфицирующие растворы, такие как Дифлазон или Димексид — это препараты, которые применяются для борьбы с грибковыми инфекциями.
Мази
Для лечения грибковых инфекций в носу часто используются лекарственные препараты в виде мазей и гелей. Они содержат специальные компоненты, борющиеся с грибком, такие как азолы и аллиламины.
К препаратам, произведенным на местности из азоловых веществ, относятся:
- Препарат Бифосин.
- Препарат Клотримазол.
- Препарат Залаин.
- Крем Низорал.
- Препарат Мазь Кандид.
Наиболее часто применяемые среди аллиламинов:
- Крем Экзодерил.
- Препарат Терминокс.
- Препарат Атифин.
- Препарат Миконорм.
- Тербинафиновый препарат.
Определение подходящего препарата зависит от чувствительности грибковой флоры.
Необходимо помнить, что избавление от грибковой инфекции – это длительный процесс, и для полного восстановления важно продолжать принимать лекарства и использовать местные средства даже после улучшения состояния.
Раствор Кандид
Препарат с широким спектром действия, который включает в себя клотримазол. Раствор Кандид эффективен против многих видов дрожжеподобных грибков и дерматофитов, а также оказывает воздействие на активность возбудителей эритразмы, стрептококков и стафилококков.
Этот препарат обычно используется для лечения молочницы в носовой полости и носоглотке, кандидозного вульвовагинита, разноцветного лишая и других заболеваний, вызванных микроорганизмами, чувствительными к клотримазолу.
Народные средства
Среди народных средств большой популярностью пользуется раствор соды, который применяется для полосканий и промывания носовых ходов. Для приготовления лечебного средства необходимо вскипятить пол-литра воды, остудить до температуры 36–37 градусов и растворить в ней одну чайную ложку пищевой соды.
Рекомендуется применять этот раствор ежедневно, от 2 до 3 раз в день.
Для облегчения симптомов грибка в носу рекомендуется применять промывания с использованием отваров трав. Чтобы избавиться от насморка, уменьшить зуд и успокоить раздраженную слизистую, рекомендуется использовать отвары ромашки, календулы, коры дуба и шиповника. Эти растворы можно закапывать в носовые ходы или использовать для смачивания ватной палочки и обработки слизистой оболочки.
Лечение ребенка
Для младенцев и маленьких детей необходимо обязательное наблюдение со стороны врача отоларинголога и детского врача.
Для терапии у детей можно применять препараты Флуконазол и Клотримазол. При необходимости врач может назначить и другие, более эффективные препараты.
Несмотря на безопасность, нельзя полагаться исключительно на народные средства в качестве лечения. Для успешного избавления от грибковой инфекции у детей необходимо использовать комплексный подход, который обязательно включает в себя применение специальных противогрибковых препаратов.
Профилактика
Для тех, кто уже сталкивался с этим заболеванием, важно регулярно проходить обследование, чтобы предотвратить повторный случай заболевания.
Самый эффективный способ предотвращения – забота о своем организме. Важно своевременно избавляться от дисбактериоза и прочих негативных аспектов.
Важно обратить внимание на витамины, которые укрепляют иммунитет. Ведь часто именно они могут вызвать появление симптомов грибка в носу. Иллюстрация заболевания представлена ниже.
Отличные результаты показали такие методики, как точечный массаж, контрастный душ и закаливание.
Необходимо тщательно следить за здоровьем зубов, поскольку воспаление и неправильное лечение могут привести к появлению кариеса.
Если несмотря на все предосторожности инфекция все же проникла в организм, то важно как можно скорее обратиться к специалисту при первых признаках заболевания. В начальной стадии болезнь легко поддается лечению, и шанс на полное излечение от грибка составляет почти 100%. В случае, если грибок перешел в тяжелую форму, вероятность рецидива существенно возрастает. Кроме того, борьба с грибком на этой стадии становится значительно сложнее. Поэтому важно постоянно следить за своим здоровьем, чтобы избежать неприятных последствий.
Как лечить
После тщательного анализа места заражения грибковыми инфекциями и установки диагноза пациент может приступить к лечению. Врач подберет наиболее подходящие препараты для пораженного носа. В качестве дополнительной терапии могут применяться средства традиционной медицины.
Лекарственные средства
Как только врач определит причину недомогания, он порекомендует пациенту начать лечение грибка в носу с применением лекарств. При своевременной помощи пациент сможет поправиться уже через несколько недель. Независимо от скорости выздоровления, через 4-6 месяцев ему следует пройти повторное лечение, чтобы предотвратить возвращение болезни.
В случаях, когда медикаментозное лечение не приносит ожидаемого результата, врачи решают провести хирургическое вмешательство. Этот метод необходим, если заболевание привело к осложнениям, например, гаймориту. Также операцию рекомендуют при сильной заложенности пазухи.
Для борьбы с грибковой инфекцией в носу применяются как местные, так и системные препараты:
- Препарат под названием «Амфотерицин В»;
- Препарат «Леворин»;
- Препарат «Бифоназол»;
- Препарат «Тербинафин»;
- Препарат «Флуконазол»;
- Препарат «Клотримазол»;
- Препарат «Итраконазол».
Самый эффективный способ борьбы с инфекцией — применение мазей и кремов. Также хорошие результаты достигаются при использовании специальных гелей от грибка в носу, которые необходимо использовать ежедневно. Для обработки наиболее удобно использовать жгутики из марли или чистые ватные палочки.

Для удобного нанесения средств местного действия на слизистую носа можно использовать ватную палочку.
Для лечения гистоплазмоза и муроромикоза необходимы хирургические вмешательства. Препараты, содержащие флуконазол, эффективно борются с молочницей. При выявлении риноспоридиоза необходима каутеризация полипов.
Помимо применения противогрибковых мазей и капель, полезно прибегнуть к витаминным комплексам. Капли и аналогичные препараты эффективно борются с проявлениями инфекции. Биологически активные добавки (БАДы) направлены на укрепление иммунной системы.
Народные средства
Лечение грибкового поражения носа возможно с помощью народных средств, которые обладают антимикотическим действием. Для борьбы с инфекцией часто применяются следующие домашние составы, приготовленные в соответствии с рецептами нетрадиционной медицины:
- Настойка из ромашки, коры дуба, череды, цветков шиповника и календулы. Этим средством следует промывать пораженное место несколько раз в течение дня;
- Свежевыжатый сок моркови или свеклы. Используйте его для смазывания слизистой оболочки носа;
- Раствор теплой воды с добавлением соды. Он предназначен для полоскания полости носа;
- Смесь витамина А с соком алоэ. Этим составом необходимо регулярно обрабатывать слизистую оболочку носа, чтобы ускорить процесс заживления тканей.
Для достижения положительного эффекта от народной терапии необходимо сочетать ее с применением традиционных аптечных препаратов.
Что такое микоз
Грибковая инфекция, известная как микоз, часто путается с вирусным насморком из-за схожих симптомов. Однако точное определение заболевания возможно только после консультации с отоларингологом и проведения диагностики.
Во всяком случае, грибковая инфекция часто является основной причиной образования большого количества слизистых выделений или воспалительного процесса в слизистой оболочке носа. Эти симптомы плохо поддаются стандартному лечению и могут усиливаться в течение нескольких недель. Чаще всего дети страдают от этого заболевания, поскольку их иммунная система еще не полностью сформирована, и организм не всегда справляется с негативным воздействием.
Также возможной причиной появления грибковой инфекции в носу может быть нарушение естественных защитных функций слизистой оболочки.
При ответе на основной вопрос, который беспокоит многих людей, а именно возможно ли наличие грибка в носу, необходимо изучить предшествующие факторы.
Очевидно, что кандидоз носоглотки является реальным заболеванием, однако важно выявить факторы, способствующие его развитию. Эта информация определяет последующее лечение и необходимые меры терапии.
Причины образования
Самые активные агенты микоза присутствуют практически в каждом организме человека, но их активация и размножение во многом зависят от образа жизни пациента. Чтобы поддерживать здоровье дыхательных путей, важно следить за увлажнением их слизистой оболочки. Если поверхность слизистой пересыхает из-за различных воздействий, в полости носа могут образоваться условия для развития патогенной флоры, которая становится благоприятной средой для размножения микробов или грибков.
Быстрое увеличение объема частиц может быть обусловлено следующими условиями:
- недостаток витаминов, который может проявиться острым;
- воспалительные заболевания, вызванные простудой;
- травмы крыльев носа или носовой перегородки;
- сахарный диабет, влияющий на состояние слизистой оболочки;
- нарушение гормонального баланса, влияющее на работу слизистой оболочки;
- изменение анатомической структуры носовой полости;
- искривление носовой перегородки, влияющее на дыхание;
- наличие полипов, мешающих нормальному дыханию;
- проблемы со зубами или наличие кариеса, влияющие на состояние слизистой оболочки.
К другим факторам, способствующим развитию микоза, относятся тяжелая форма дисбактериоза кишечника, а также неправильное лечение воспалительных процессов в ЛОР-органах. К этой же группе причин относятся неправильное использование антибактериальных препаратов или игнорирование необходимости приема пребиотиков.
В дополнение, вызвать появление грибка в носу у ребенка или взрослого может купание в загрязненных реках или водоемах, а также частое использование различных препаратов для сужения сосудов.
Важно помнить, что использование различных капель и спреев без предварительной консультации с врачом недопустимо. В противном случае это может привести к развитию грибковой инфекции в носу.
Таким образом, мы убедились в том, что микоз – это не выдумка и такая форма заболевания действительно существует. В данной ситуации важно не пренебрегать процессом размножения грибка в носу, а распознать признаки воспаления и приступить к необходимой терапии.
Обратите внимание на изображение воспалительного процесса:
Симптоматика воспаления
Признаки грибковой инфекции в носу могут отличаться в каждом конкретном случае, однако существует общая клиническая картина. Она позволяет определить степень воспаления и тип заболевания, хотя симптомы во многом зависят от конкретного грибка и его вида.
При изучении состава в носовой полости, медицинские специалисты определят тип микроорганизмов и разработают план дальнейшего лечения.
В общем, когда грибковая инфекция развивается в носовой полости, пациенты сообщают о следующих признаках:
- неприятный запах изо рта;
- ощущение жжения и зуда в носовой полости;
- появление головокружения;
- изменение звучания голоса;
- обильные выделения слизи;
- кровотечения из носа;
- образование гнойных образований;
- ухудшение обоняния;
- развитие трахеита и бронхита;
- обильные зеленые или желтые слизистые выделения;
- затрудненное дыхание через нос;
- продолжительный насморк;
- неприятные ощущения внутри полости носа;
- образование микротрещин и язв;
- интенсивные выделения из ран в полости носа;
- нарушение многих функций в полости носоглотки;
- образование полипов;
- нарушение целостности носовой перегородки;
- анатомические изменения в строении лица.
Честно говоря, следует отметить, что эти два признака проявляются лишь на поздних стадиях. При распространении воспаления возможно появление ангины или грибкового тонзиллита.
В течение всего процесса заболевания люди замечают появление значительной усталости, сонливости и слабости. Часто инфекционный грибок сопровождается повышенной температурой.
Стандартное лечение
Для определения причин назначение дальнейшего лечения необходимо. Современные методы медицины способны быстро избавить от недуга, при условии соблюдения всех рекомендаций пациентом.
Помните, что процесс избавления от грибка займет от двух до четырех недель. Однако, если инфекция перешла на более серьезные стадии, может потребоваться до двух месяцев лечения.
Медицинские специалисты советуют не останавливаться на этом и через три месяца после завершения лечения обратиться за еще одной консультацией.
Рецидивы микоза часто возникают снова, поэтому важно принимать меры для их предотвращения.
В случаях, когда грибок в носу становится более сложным и запущенным, его устранение может потребовать проведения операции.
Однако, если вы своевременно обратились за медицинской помощью, то врач предложит лечение с применением лекарств. Это включает в себя препараты для местного применения, а также антибактериальные препараты, такие как Амфотерицин В, Тербинафин, Флуконазол, Бифоназол, Итраконазол.
Каждый день следует применять разнообразные мази, предназначенные для ухода за носовой полостью. Вводить их в нос нужно исключительно с использованием стерильных палочек или жгутиков из марли. Повторять эти процедуры рекомендуется как минимум дважды в сутки.
Для борьбы с грибковыми инфекциями рекомендуется использовать препараты из группы полиенов, такие как Нистатин, Леворин, Пимафуцин. Если возникает повышенная чувствительность или аллергические реакции, то следует подобрать альтернативные препараты или изменить метод лечения. В этом случае можно рассмотреть возможность применения Амбизом, Амфоглюкамин, Амфоцил или Фунгизон.
Необходимо использовать определенные противогрибковые препараты для лечения грибковых инфекций в носу, такие как Ирунин, Итразол, Кандитрал, Орунгал, Румикоз, Орунит. Они помогут устранить воспалительный процесс и предотвратить повторное возникновение заболевания.
На рынке представлено большое количество капель от грибковой инфекции в носу, однако медики настаивают на использовании только определенных препаратов.
Этот лекарственный средство благоприятно воздействует на организм в ходе операции, способствуя сокращению времени реабилитации.
Когда полипы образуются в носу, первоочередной задачей является удаление этих новообразований, прежде чем назначать пациенту дальнейшее лечение.
Во время всего периода лечения пациенту требуются общеукрепляющие препараты: Активанад-Н, Аскофол, Витамакс, Галенофиллипт или Кропанол. Иногда эти препараты заменяют на Милайф или Простопин.
Лечение грибковой инфекции в носу
Лечение инфекции грибком в носу требует обязательной консультации врача. Самостоятельное лечение может привести к серьезным последствиям, таким как потеря обоняния, повреждение носовой перегородки и некротические процессы в тканях лица. В редких случаях возможно образование опухолей. Лечебные методы направлены на устранение симптомов заболевания, уничтожение грибковой инфекции и восстановление иммунитета для предотвращения возможных рецидивов. При наличии полипов их удаляют хирургическим путем.
Синтетические препараты
Антимикотики имеют различную степень воздействия на организм. Их можно классифицировать следующим образом:
- Препараты для местного применения используются внешне и помогают устранить симптомы заболевания, особенно на ранней стадии.
- Системные препараты являются более мощными средствами, оказывающими воздействие на весь организм. Однако их высокая токсичность ограничивает применение только у взрослых пациентов.
Местные лекарства
Этот препарат эффективен не только в лечении пораженных участков, но также помогает предотвратить развитие грибковых заболеваний.
Для избавления от грибковой инфекции в слизистой оболочке носа можно применять различные местные препараты:
- «Препарат Кандид»;
- «Антимикотик Клотримазол»;
- «Противогрибковый препарат Пимафуцин»;
- «Препарат Нистатин»;
- «Антимикотик Леворин»;
- «Противогрибковый препарат Бифоназол»;
- «Антисептик Фурациллин»;
- «Препарат Димексид»;
- «Противогрибковый препарат Дифлазон»;
- раствор йода (при наличии грибковых проявлений на коже крыльев носа);
- бура в глицерине (эффективное средство при наличии кандиды в носу).
;
Системные средства
Излечить хронические грибковые заболевания помогают препараты, оказывающие системное воздействие на организм. Лекарства представлены в виде таблеток, капсул и растворов для внутривенного введения. Существуют эффективные средства, способные преодолеть грибковую инфекцию:
- Препарат под названием «Дифлюкан»;
- Препарат «Орунгал»;
- Препарат «Гризеовульфин»;
- Препарат «Тербинафин»;
- Препарат «Итраконазол»;
- Препарат «Кетоконазол».
Лечение народным средством
Лечение грибковой инфекции в носоглотке возможно при помощи народных средств на ранних стадиях заболевания. Применение таких методов следует начинать только после консультации с врачом. Вот несколько рецептов от грибковой инфекции:
- Соль морская. Капли, приготовленные на основе раствора морской соли в воде (1 столовая ложка соли на стакан воды), использовать в каждый носовой проход по 3—4 раза в день.
- Масло чайного дерева. Тампоны, смоченные в смеси оливкового и масла чайного дерева, помещать в носовые проходы на полчаса 1 раз в день.
- Свежий сок свеклы и/или моркови. Наносить по 2—3 капли 1 раз в день.
- Сода. 1 чайная ложка соды, 2 капли йода и 200 мл воды смешать и использовать для промывания носа ежедневно от грибка.
- Кора дуба. Отвар коры дуба (2 столовые ложки на 250 мл воды, прокипятить, настоять час, остудить, процедить) промывать носовые пазухи утром и вечером.
- Календула. Смесь трав календулы, ромашки и эвкалипта отварить, процедить. Вливать в каждый носовой проход по 10 мл ежедневно до исчезновения грибка.
- Сок алоэ с добавлением жидкого витамина А в равных пропорциях применять для смазывания слизистой при грибке.
Народные средства лечения и профилактика
Использование народных средств может помочь избавиться от последствий заболевания микозом и заражения спорами грибка, так как они оказывают антимикотическое воздействие на организм.
Для достижения хороших результатов можно использовать домашние средства, приготовленные согласно следующим рецептам:
- Сок из свежих свеклы или моркови можно использовать для ежедневного смазывания слизистой оболочки носа несколько раз в день.
- Для промывания пораженной зоны можно использовать отвар из травы череды, календулы, дубовой коры, ромашки и цветков шиповника, взятых в одинаковом количестве.
- Добавьте небольшое количество соды в теплую воду и используйте получившийся раствор для промывания носа.
- Добавьте несколько капель витамина А в сок алоэ и используйте эту смесь для ускорения регенерации тканей при смазывании.
Когда вы прибегаете к народным средствам, не следует игнорировать медикаментозные препараты, поскольку именно таким образом можно достичь хороших результатов.
Людям, у которых уже был грибковый насморк или тем, кто хочет уменьшить вероятность заболевания, специалисты по отоларингологии советуют заняться профилактикой:
- укрепить защитные функции иммунной системы;
- положительно сказывается на общем самочувствии закаливание организма;
- регулярно посещать стоматолога и следить за здоровьем полости рта;
- поддерживать правильное питание, а также контролировать, чтобы организм получал необходимые витамины и другие полезные вещества вместе с пищей;
- поддерживать здоровый образ жизни.
Инфекция носовой полости — это заболевание, вызванное поражением слизистой оболочки грибковыми спорами. Оно представляет опасность для здоровья дыхательных путей, поэтому важно обеспечить своевременное лечение, назначенное после проведения диагностики.
Частые вопросы
Какие симптомы грибка в носу могут возникнуть?
Симптомы грибка в носу могут включать зуд, раздражение, отек слизистой оболочки, неприятный запах, выделения из носа и дискомфорт при дыхании.
Как можно лечить грибок в носу?
Лечение грибка в носу может включать применение антимикотических мазей или капель, промывание носа специальными растворами, прием системных противогрибковых препаратов по назначению врача.
Полезные советы
СОВЕТ №1
При появлении симптомов грибка в носу, таких как зуд, раздражение, отделяемый из носа, обратитесь к оториноларингологу для точного диагноза и лечения.
СОВЕТ №2
Следуйте рекомендациям врача относительно лечения грибка в носу, включая применение антимикотических препаратов, местных средств и соблюдение гигиены носовых проходов.
СОВЕТ №3
Избегайте самолечения и использования народных средств без консультации с врачом, так как это может ухудшить состояние и привести к осложнениям.